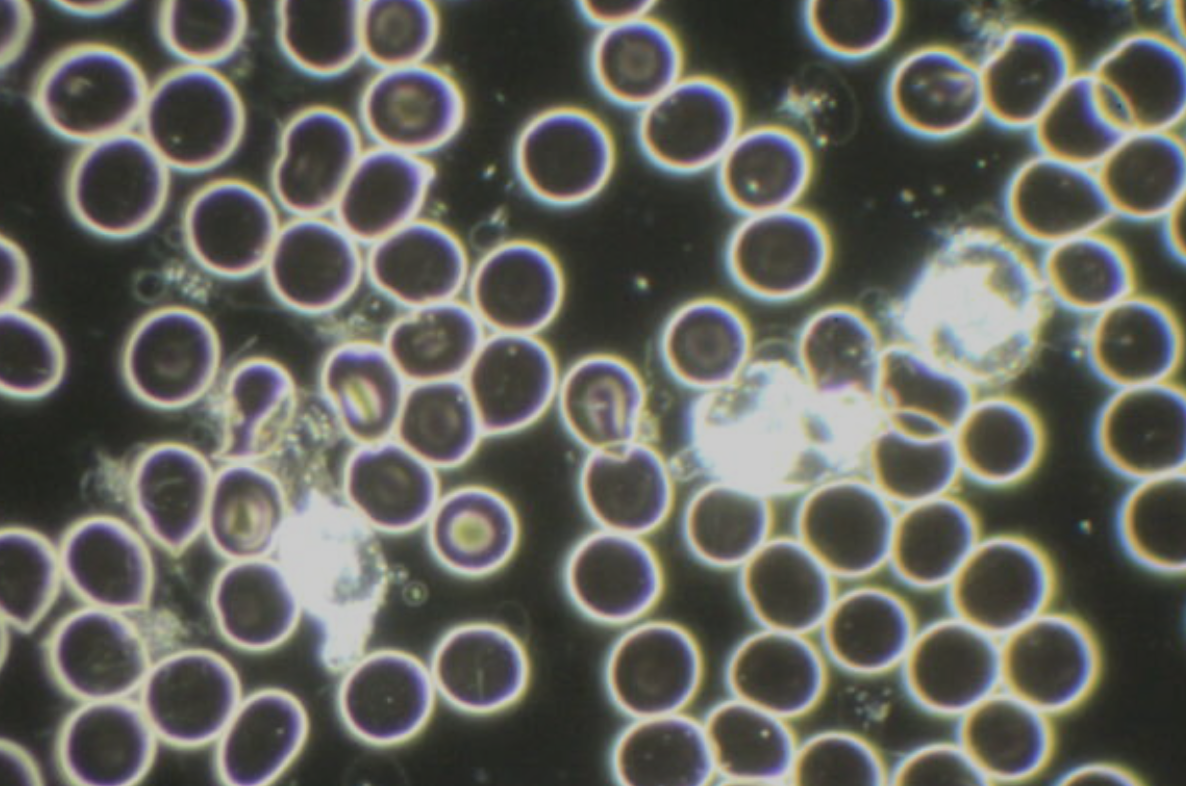
Microscopic view of numerous small, round cells or particles, some glowing or bright, scattered across a dark background.

Live Blood Cell Analysis
Real-time microscopic blood health screening.
Live Blood Cell Analysis
What is it?
Live Blood Cell Analysis (LBA) involves observing a drop of freshly drawn blood under a specialized microscope with magnification up to 10,000 times. The blood is examined in real-time using a dark field or phase contrast video microscope, allowing for detailed observation of red blood cells and their activity.
This method reveals subtle changes in the blood that reflect the internal environment—or "terrain"—of the body. When this terrain is imbalanced due to toxins, nutrient deficiencies, or poor hydration, it can lead to various health concerns such as lowered immunity, bowel issues, and susceptibility to infections.
Benefits
Early Detection: Potential health issues may be detected before symptoms appear.
Cellular Health Insight: Identifies poor hydration, oxidized or misshapen red blood cells, cellular debris, parasites, and more.
Supportive Tool: Can assist in creating a targeted plan for improved health through diet, lifestyle, and supplement adjustments.


Uses for Live Blood Cell Analysis
Nutritional Assessment: Identifies deficiencies in nutrients such as vitamin B12, folic acid, and fatty acids, helping to tailor dietary recommendations.
Immune Function Evaluation: Offers insight into how well the immune system is functioning by analyzing red and white blood cells.
Toxin & Pathogen Detection: May show signs of toxins or pathogens in the blood.
Health Monitoring: Tracks changes in blood health over time, helping to evaluate the effectiveness of lifestyle or treatment plans.

What to Expect
You’ll be able to view your blood in real-time and discuss what’s seen on screen with a practitioner. Recommendations may include dietary changes, hydration, detoxification, or nutritional support.
Before Your Appointment
For the most accurate results, you must fast from everything except water for 4 hours before your appointment.
Dry Blood Cell Analysis
What It Is
Dry Blood Cell Analysis involves drying small drops of blood on a slide and examining them under a microscope. This test is often used to observe the oxidative stress level in the blood and the overall internal health.
What We Look For
Oxidative Stress Patterns: Indicates the body’s ability to manage free radicals and inflammation.
Nutritional Deficiencies: Can highlight vitamin or mineral shortages.
Hydration Levels: Observes dehydration or poor water retention.
Digestive Health: Insight into digestion and possible toxic build-up.
Immune System Performance: Assesses how well the body’s immune defense is functioning.
Understanding Your Results
By comparing your results to established patterns, this analysis can help you and your practitioner better understand areas for improvement in your health. Over time, follow-up visits may show how your health is changing and help tailor further dietary or lifestyle adjustments.

